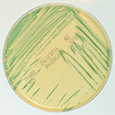

Le projet EcoSec

Le projet EcoSec vise à réduire l’impact environnemental des opérations d’hygiène dans les ateliers de traitement des aliments réfrigérés, au moyen d’une utilisation optimisée de la déshumidification de l’air.
Contexte
 Le nettoyage et la désinfection (N&D) sont parmi les plus importantes mesures de maîtrise des dangers dans les ateliers de fabrication de produits réfrigérés prêts à être consommés. Cependant, ces opérations consomment de grands volumes d’eau et produisent des quantités considérables de rejets chargés en agents de nettoyage et en désinfectants. Certains d’entre eux peuvent en outre provoquer des dermatoses professionnelles. Il est donc nécessaire de mettre au point des stratégies durables de N&D. Des exploitants du secteur alimentaire ont déjà constaté les avantages apportés par un séchage des surfaces par déshumidification de l’air après N&D. Ceci permet de réduire la survie et de maîtriser la croissance des micro-organismes non éliminés par le N&D. Toutefois le séchage par l’air est à ce jour pratiqué de façon empirique, sans chercher à optimiser le processus de déshumidification.
Le nettoyage et la désinfection (N&D) sont parmi les plus importantes mesures de maîtrise des dangers dans les ateliers de fabrication de produits réfrigérés prêts à être consommés. Cependant, ces opérations consomment de grands volumes d’eau et produisent des quantités considérables de rejets chargés en agents de nettoyage et en désinfectants. Certains d’entre eux peuvent en outre provoquer des dermatoses professionnelles. Il est donc nécessaire de mettre au point des stratégies durables de N&D. Des exploitants du secteur alimentaire ont déjà constaté les avantages apportés par un séchage des surfaces par déshumidification de l’air après N&D. Ceci permet de réduire la survie et de maîtriser la croissance des micro-organismes non éliminés par le N&D. Toutefois le séchage par l’air est à ce jour pratiqué de façon empirique, sans chercher à optimiser le processus de déshumidification.
Listeria monocytogenes est la bactérie pathogène la plus redoutée dans les ateliers de fabrication d’aliments réfrigérés : la listériose a un taux élevé de létalité, compris entre 20 et 30%, et la bactérie peut persister même quand le nettoyage et la désinfection sont correctement appliqués. En outre, L. monocytogenes est peu sensible à la dessiccation. Cette espèce a donc été choisie pour déterminer les meilleures stratégies de séchage et acquérir des connaissances sur les réponses aux perturbations hydriques et sur le phénomène de persistance bactérienne.
Listeria monocytogenes est la bactérie pathogène la plus redoutée dans les ateliers de fabrication d’aliments réfrigérés : la listériose a un taux élevé de létalité, compris entre 20 et 30%, et la bactérie peut persister même quand le nettoyage et la désinfection sont correctement appliqués. En outre, L. monocytogenes est peu sensible à la dessiccation. Cette espèce a donc été choisie pour déterminer les meilleures stratégies de séchage et acquérir des connaissances sur les réponses aux perturbations hydriques et sur le phénomène de persistance bactérienne.
 L’écoulement de l’air et les conditions climatiques sur les différentes surfaces d’un atelier ont un impact sur le séchage et donc sur la survie des bactéries non éliminées par le N&D. Il est donc prévu d’étudier ces phénomènes à l’échelle du grand volume que représente un atelier de fabrication. En outre, un à deux tiers de l’énergie de traitement de l’air peuvent être consacrés à la maîtrise de l’humidité notamment par la technique du froid mécanique qui est la plus utilisée. C’est pourquoi d’autres techniques moins consommatrices en énergie, dont une qui utilise des solutions dessiccantes seront étudiées au cours de ce projet.
L’écoulement de l’air et les conditions climatiques sur les différentes surfaces d’un atelier ont un impact sur le séchage et donc sur la survie des bactéries non éliminées par le N&D. Il est donc prévu d’étudier ces phénomènes à l’échelle du grand volume que représente un atelier de fabrication. En outre, un à deux tiers de l’énergie de traitement de l’air peuvent être consacrés à la maîtrise de l’humidité notamment par la technique du froid mécanique qui est la plus utilisée. C’est pourquoi d’autres techniques moins consommatrices en énergie, dont une qui utilise des solutions dessiccantes seront étudiées au cours de ce projet.
Les objectifs du projet
Objectifs opérationnels
-
Définir des conditions optimales de déshumidification de l’air pour
- l’inactivation de L. monocytogenes,
- la distribution de l’humidité relative, de la température et de la vitesse de l’air dans un atelier de fabrication.
- la durabilité de la technique de séchage de l’air
-
Le projet évaluera dans quelle mesure cette optimisation permettra
- l’emploi de produits respectueux de l’environnement pour le N&D,
- la réduction de la fréquence des désinfections et donc le volume des rejets et l’émission de biocides,
sans affecter la sécurité des aliments ou même en améliorant cette dernière et la santé au travail.
Objectifs scientifiques
- Evaluer l’impact du séchage sur la mortalité, la résistance et l’adaptation de Listeria monocytogenes.
- Décrire et comprendre les mécanismes cellulaires (impliquant la membrane plasmique) et moléculaires aux niveaux transcriptomique, lipidomique et protéomique ;
- Identifier des marqueurs de viabilité afin de développer un outil permettant de détecter, dans les environnements industriels, les cellules non détectables par culture ;
- Etudier l’impact de la dessiccation sur le potentiel de persistance de L. monocytogenes sur la base de modélisations expérimentale et mathématique. Ces dernières teindront compte des multiples conditions que peut rencontrer la bactérie (microflore associée, nature des souillures alimentaires, état géométrique de surface des matériaux, nature des produits d’hygiène etc.)
- Développer un outil numérique pour caractériser les points chauds, les zones humides, les zones à fortes ou faibles vitesses d’air dans un grand volume réfrigéré afin de fournir un outil d’optimisation aux opérateurs et ainsi définir les configurations maximisant la mortalité bactérienne sur les surfaces.
- Comparer les techniques de déshumidification de l’air en termes de consommation d’énergie et de flexibilité afin de proposer des techniques durables adaptées aux objectifs de sécurité sanitaire des aliments.
Les partenaires

 |
Anses - Laboratoire de sécurité des aliments | Brigitte Carpentier |
 |
Unité de Procédés alimentaires et microbiologiques, Dijon (PAM) | Laurent Beney |
 |
Institut national de la recherche agronomique, Theix (INRA) | Michel Hébraud |
 |
Institut national de recherche en sciences et technologies de l'environnement et l'agriculture, Antony | Onrawee Laguerre |
 |
Maison du Froid Conseil, St Parres aux Tertres (MF Conseil) | Jacques Guilpart |
 |
DESSICA, Trévoux | Adam Tchaïkowski |
 |
Groupe Labeyrie Fine Foods, Came | Yves Gasnier |
Voir la présentation du projet EcoSec en vidéo :
Séminaire nettoyage et désinfection décembre 2014 :
Consultez les présentations.
- Présentation du projet EcoSec - Olivier Firmesse (Anses)
- Listeria : 20 ans de travail et la lutte continue ! - Yves Gasnier (Groupe Labeyrie)
- Le séchage des ateliers : quelles technologies et quels couts énergétiques ? - Jacques Guilpart (MF Conseil) et Adam Tchaikowski (Dessica)
- Matériaux : tous égaux face aux opérations d’hygiène ? - Anaïs Overney (Anses)
- Analyse protéomique de la réponse adaptative de biofilms de Listeria monocytogenes soumis à un stress de dessiccation - Michel Hébraud (Inra)
- Maîtrise de l’humidité relative sur la survie de Listeria monocytogenes - Fiona Zoz (Université de Bourgogne, AgroSup Dijon)
- Caractérisation de l’évaporation d’eau d’une surface mouillée pour la maîtrise d’humidité dans une enceinte réfrigérée - Onrawee Laguerre (Irstea)
Séminaire du 1er octobre 2015 à Clermont-Ferrand.
Consultez le programme (pdf)
-
Présentation du projet EcoSec - Olivier Firmesse (Anses)
.png)
- Listeria : 20 ans de travail et la lutte continue ! - Yves Gasnier (Groupe Labeyrie)
- Le nettoyage-désinfection dans l'univers agroalimentaire viande, nécessité et contraintes - Pierre Beaubois (Groupe Socopa)
- Nouvelles technologies alternatives à la désinfection chimique : intérêts-limites-avenir - Souad Christieans (Adiv)
- Le séchage des ateliers : quelles technologies et quels couts énergétiques ? - Jacques Guilpart (MF Conseil) et Adam Tchaikowski (Dessica)
- Efficacité de la déshumidification de l'air dans un atelier alimentaire - Logan Lecoq (Irstea)
- Décontamination microbienne des surfaces : impact de l'humidité relative sur la viabilité et la physiologie de L. monocytogenes - Fiona Zoz (Université de Bourgogne, AgroSup Dijon)
- Comment décrypter les mécanismes moléculaires d'adaptation à la dessiccation de L. monocytogenes en biofilm ? - Michel Hébraud (Inra)
- Le séchage peut-il empêcher la persistance de L. monocytogenes dans les ateliers ? - Anaïs Overney (Anses)
- Modéliser et prévoir la persistance bactérienne dans l'environnement, un défi insurmontable ? - Laurent Guillier (Anses)
Pour tout renseignement, contacter Alexandre THILLIER ou Olivier FIRMESSE




